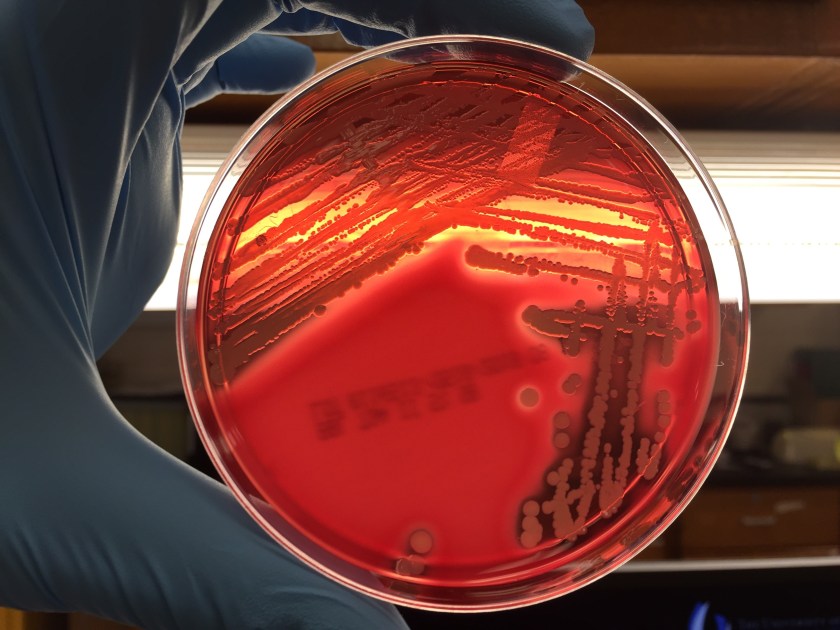
visa1.jpg
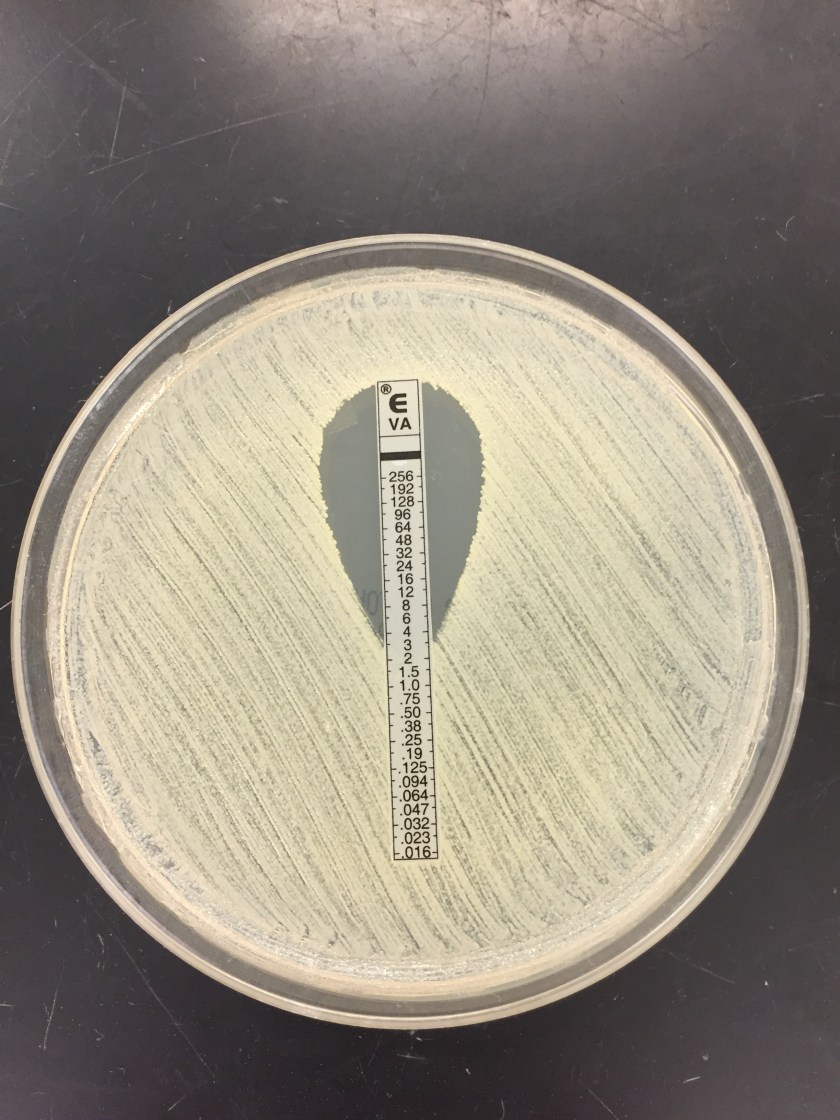
visa2.jpg

Case History
A 37 year old African American male was transferred from an outside hospital due to mitral valve endocarditis. His past medical history was significant for diabetes mellitus type II and end stage renal disease requiring long-term dialysis. Four months prior, he was bacteremic with methicillin resistant Staphylococcus aureus and received IV vancomycin therapy. At admission, his temperature was 102.1°F and labs revealed a white blood cell count of 25.3 TH/cm2 with 95% neutrophils and a left shift, a normocytic anemia, and a creatinine of 5.39 mg/dL. Physical exam revealed a severe mitral valve regurgitation. Various imaging modalities showed vegetations on the mitral valve, complete occlusion of the distal infrarenal abdominal aorta, several subacute infarcts in the brain, multiple sites of osteomyelitis of the spine, and a pelvic bone abscess. After collecting initial blood cultures, vancomycin and cefepime were started.
Laboratory Identification

Multiple blood cultures were positive and Staphylococcus aureus was identified by MALDI-TOF mass spectrometry (Image 1). Susceptibility testing of the isolate showed resistance to cefoxitin and oxacillin, consistent with methicillin resistant S. aureus (MRSA). Due to a vancomycin MIC of 2 ug/ml by broth microdilution, an Etest was set up and results showed an MIC of 3 ug/ml (Image 2). Rounded up to next doubling dilution, this resulted in a MIC of 4 ug/dl, which was concerning for a vancomycin intermediate S. aureus (VISA). Repeat identification and susceptibility testing confirmed these findings. For this reason, the isolate was sent to the department of health for confirmatory testing.
Discussion
Vancomycin is the first line agent for treating infections caused by methicillin resistant S. aureus (MRSA). When MRSA isolates show reduced susceptibility results to vancomycin, they are classified as vancomycin intermediate S. aureus (VISA) or vancomycin resistant S. aureus (VRSA). This phenomenon is concerning, as it leaves clinicians with relatively few therapeutic options. Broad spectrum antibiotics such as daptomycin, linezolid, or 5th generation cephalosporins (ceftaroline & ceftobiprobe) are potential treatment selections in these cases.
The Clinical and Laboratory Standards Institute (CLSI) has set the following MIC breakpoints for vancomycin in relation to S. aureus: ≤2 ug/ml susceptible, 4-8 ug/ml intermediate, and ≥16 resistant. If elevated vancomycin MICs are encountered in the laboratory, the isolate should be checked for purity, the organism identification should be confirmed, and susceptibility testing repeated. The laboratory should notify the state health department and hospital infection prevention team if a VISA or VRSA is suspected. Further testing of the isolate by the health department and/or CDC is required. Appropriate infection control measures, such as wearing gowns & gloves and adherence to hand hygiene, should be taken to decrease the spread of VISA/VRSA, as treatment options are limited.
While not fully understood, the reduced vancomycin susceptibility in VISA isolates is thought to be due to an abnormally thickened peptidoglycan cell wall that makes it more difficult for vancomycin to reach the cell membrane and inhibit cell growth. On the other hand, VRSA isolates most commonly acquire the vanA vancomycin resistance gene from Enterococcus faecium, which confers high-level vancomycin resistance. Usually those with VRSA infections previously have been infected with both VRE and MRSA. This co-infection allows for the vanA gene to be transferred by a plasmid or transposon from the VRE to the MRSA isolate, resulting in a S. aureus isolate that is now resistant to vancomycin.
In the case of our patient, further testing by the health department showed his MRSA isolate had a vancomycin MIC of 2 ug/ml by broth microdilution (susceptible) and an MIC 3 ug/ml by Etest. It was noted these results were within a single doubling dilution. As broth micro dilution is the reference method, his isolate was considered susceptible to vancomycin. However, the elevated MICs by both methods suggest the isolate is developing reduced susceptibility to vancomycin. Due to septic emboli in various organs, he was not a surgical candidate and was managed medically with ceftaroline and linezolid.

-Jaswinder Kaur, MD, is a fourth year Anatomic and Clinical Pathology chief resident at the University of Mississippi Medical Center.

-Lisa Stempak, MD, is an Assistant Professor of Pathology at the University of Mississippi Medical Center in Jackson, MS. She is certified by the American Board of Pathology in Anatomic and Clinical Pathology as well as Medical Microbiology. She is the Director of Clinical Pathology as well as the Microbiology and Serology Laboratories. Her interests include infectious disease histology, process and quality improvement, and resident education.
Thanks it is v.helpful.I love your blog..
Is there any other blog where I can get such clinical knowledge of microbiology
Dr Rachna Tewari
MD Microbiology